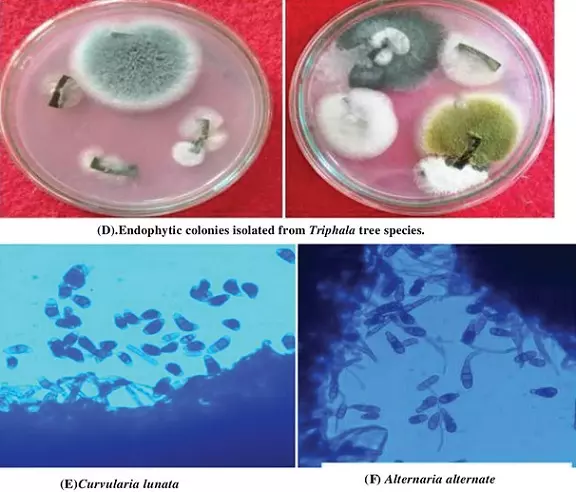
Graphical Abstract
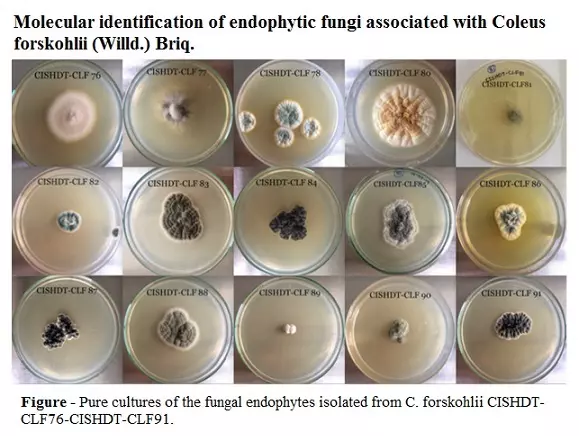
Graphical Abstract

Bioactivity assessment of endophytic fungi associated with Centella asiatica and Murraya koengii
Archana Nath, Jyoti Pathak and SR Joshi
DOI: 10.7324/JABB.2014.2502Pages: 006-011

Screening, Selection and Optimization of the Culture Conditions for Tannase Production by Endophytic Fungi Isolated from Caatinga
Rayza Morganna Farias Cavalcanti, Pedro Henrique de Oliveira Ornela, João Atílio Jorge, Luís Henrique Souza Guimarães
DOI: 10.7324/JABB.2017.50101Pages: 001-009

In vitro antagonistic activity of a root endophytic fungus towards plant pathogenic fungi
K. Talapatra, A. Roy Das, A. K. Saha, P. Das
DOI: 10.7324/JABB.2017.50210Pages: 068-071

Distribution and diversity of endophytic fungi associated with three medicinal tree species from Eturnagaram Wildlife Sanctuary, TS, India
Bhavani Vemireddy, Abhinesh Madasi, Aruna Ajmeera, Krishna Reddy Vanteru
DOI: 10.7324/JABB.2020.80602Pages: 7-12
Molecular identification of endophytic fungi associated with Coleus forskohlii (Willd.) Briq.
Grace Leena Crasta, Koteshwar Anandrao Raveesha
DOI: 10.7324/JABB.2021.96021Pages: 162-172
Endophytic Fungi as Emerging Bioresources for Bioactive Compounds for Sustainable Development
Divjot Kour, Neelam Yadav, Ajar Nath Yadav
DOI: 10.7324/JABB.2023.111edPages: i-iii

Plant growth-promoting potential of Diaporthe osmanthi COFS1, an endophyte of Coleus forskohlii
Riya Dutta, Debdulal Banerjee
DOI: 10.7324/JABB.2025.215296Pages: 159-169
